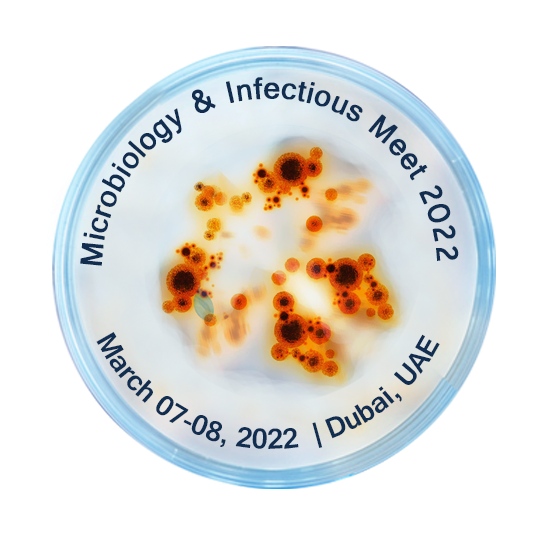

With the grand success from the previous relevant worldwide conferences, Aver Conferences is organizing “International Conference on Microbiology & Infectious Diseases" scheduled during March 07-08, 2022 at Dubai, UAE.
Microbiology & Infectious Meet 2022 brings together the global leaders in Microbiology & Infectious Diseases fields to present their research at this exclusive scientific program. The conference delivers an opportunity to researchers and experts to discover the basic, innovative and latest research developments in the field of Current Trends in Microbiology and Infectious Diseases.
Microbiology & Infectious Meet 2022 brings together the global leaders in Microbiology & Infectious Diseases fields to present their research at this exclusive scientific program. The conference delivers an opportunity to researchers and experts to discover the basic, innovative and latest research developments in the field of Current Trends in Microbiology and Infectious Diseases.